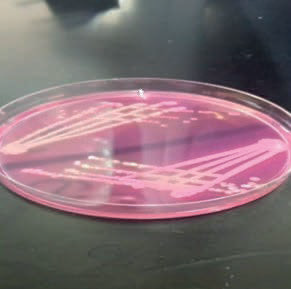

Antimicrobial susceptibility of Escherichia Coli and Salmonella spp (Kenya)
Multidrug resistance of Escherichia coli and Salmonella spp has increased in the recent years and this has led to resistance of the microorganisms to antimicrobials. The main objective of the study was to evaluate antimicrobial resistant strains of E. coli and Salmonella spp isolated from sanitation environments of Majengo Slum in Meru County, Kenya. The specific objective for the study was to determine the susceptibility patterns of various antibiotics to Escherichia coli and Salmonella spp in the study site. The study employed standard microbiological procedures of culturing, biochemical testing for confirmation and susceptibility profile on Muller Hinton agar. Data was entered into Microsoft Excel 2010 and analyzed using SPSS version 26. Data was compared between each study strata and between each sample type using Kruskal-Wallis tests, and between the two drugs using the Wilcoxon Signed Rank tests. Statistical analysis revealed a significance in comparison between the two strata studied. Highest resistance was shown to Cefoxitin (52.4%) and the least to Ciprofloxacin (9.5%). Ceftazidime showed highest sensitivity (66.7%) while Cefoxitin showed least sensitivity (31.0%). This study showed that E. coli isolated is pathogenic and resistant to antibiotics. Detection of E. coli poses a great risk in the spread of resistant strains.

